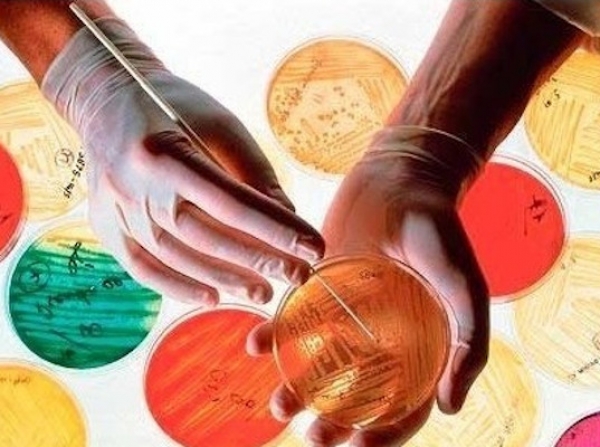

Постановлением Правительства РФ от 01.06.2021 N 851 "О внесении изменений в Постановление Правительства Российской Федерации от 15 сентября 2008 г. N 688" внесены дополнения
Раздел II перечня кодов медицинских товаров в соответствии с ОКПД, облагаемых НДС по ставке 10% при их реализации, дополнены кодами:
- 20.59.52.150 Среды питательные для диагностики in vitro;
- 20.59.52.195 Реагенты для определения аналитов для диагностики in vitro;
- 25.99.29.140 Контейнеры опасных медицинских отходов металлические;
- 32.50.50.149 Урологические медицинские изделия прочие.
Раздел II перечня кодов медицинских товаров в соответствии с ТН ВЭД ЕАЭС, облагаемых НДС по ставке 10% при их ввозе в РФ, дополнены кодами:
- 3821 00 000 0 Среды питательные для диагностики in vitro;
- 7310 10 000 0; 7310 29; 7326 90 940 9; 7326 90 980 7 Контейнеры опасных медицинских отходов металлические;
- 9021 90 900 9 Пессарии акушерские и урогинекологические;
- 9619 00 Пеленки (простыни) впитывающие одноразовые; пеленки медицинские впитывающие одноразовые для ухода за взрослыми, детьми и новорожденными; подгузники детские медицинские; подгузники для взрослых; прокладки урологические.